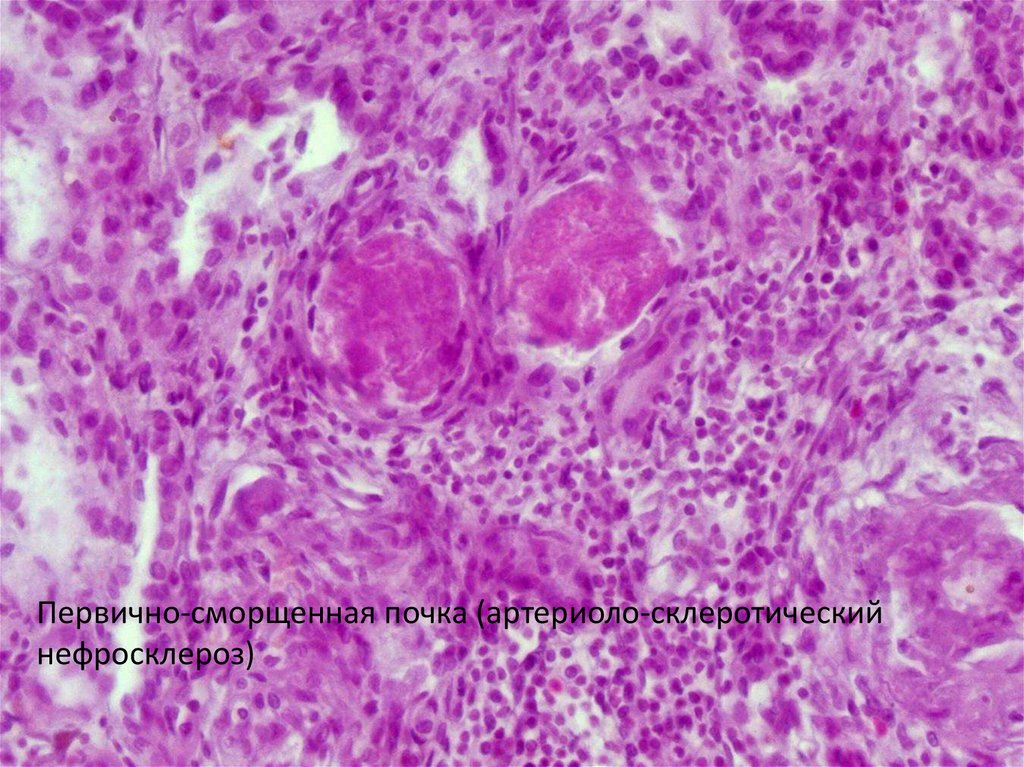
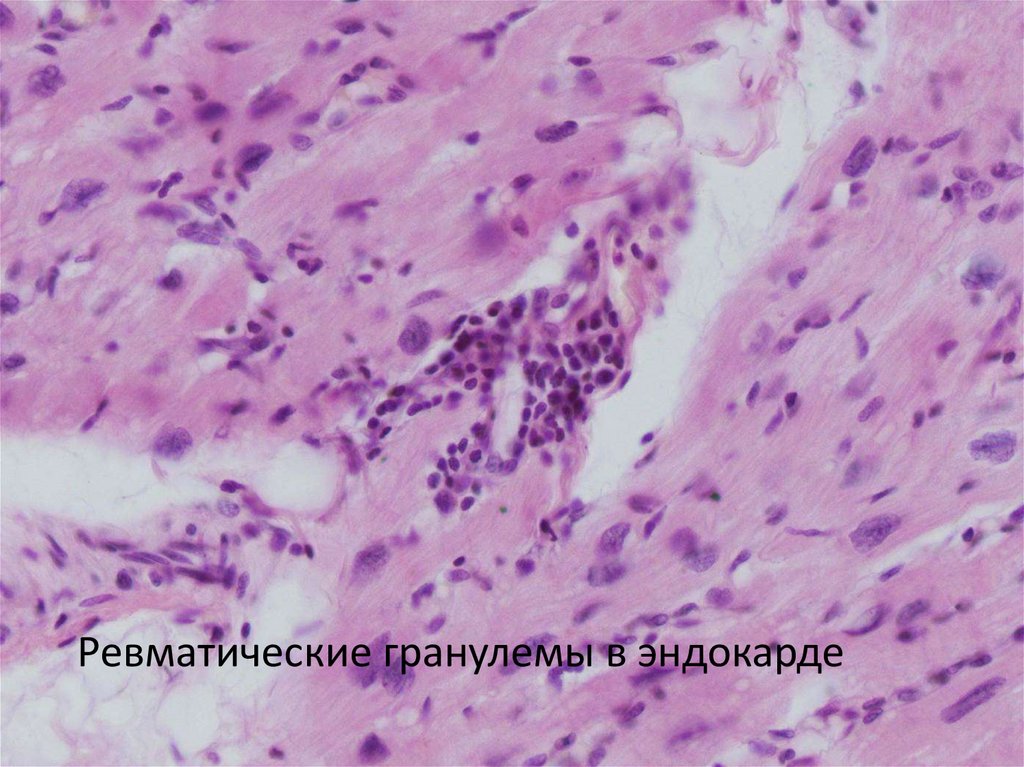
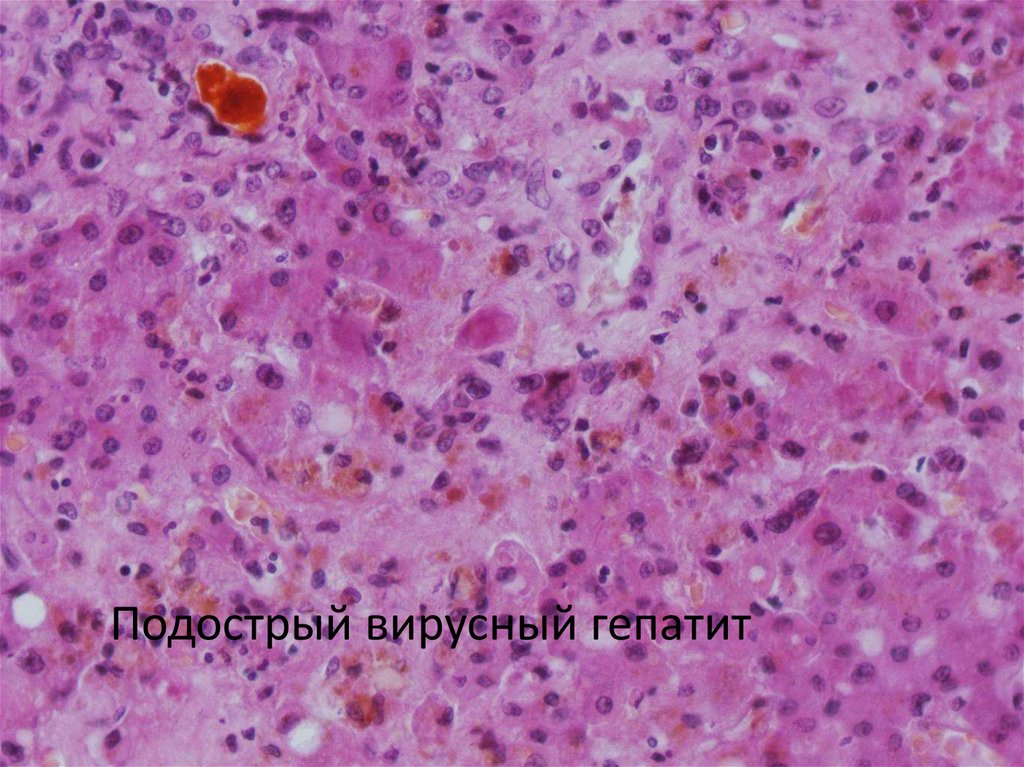

Похожие презентации:
Атеросклероз. Ишемическая болезнь сердца
1.
Атеросклероз. Ишемическаяболезнь сердца.
2.
Тромбоз коронарной артерии сердца3.
Постинфарктный кардиосклероз. Хроническаяишемическая болезнь сердца
4.
Атеросклероз аорты. Стадии липоидоза иатерокальциноза (окр. Судан III)
5.
Гипертоническая болезнь6.
Плазморрагия сосудов головного мозга ипетехии
7.
Кровоизлияние в мозг8.
Первично-сморщенная почка (артериоло-склеротическийнефросклероз)
9.
Ревматические болезни (коллагенозы). Пороки сердца.10.
Ревматические гранулемы в эндокарде11.
Склерозированный клапан с петрификацией12.
Фибринозный перикардит13.
Болезни почек14.
Экссудативный (серозный) экстракапиллярныйгломерулонефрит
15.
Пролиферативный интракапиллярныйгломерулонефрит

Медицина
Медицина








